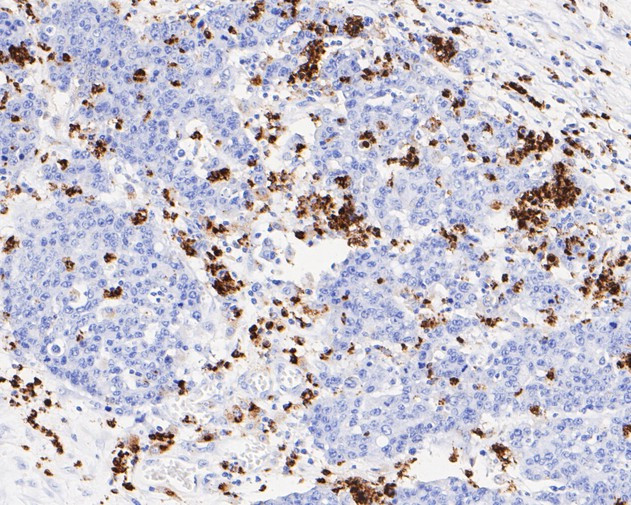
Lysozyme Antibody in Immunohistochemistry (Paraffin) (IHC (P))

Search
Invitrogen
Lysozyme Monoclonal Antibody (A5A8)
{{$productOrderCtrl.translations['antibody.pdp.commerceCard.promotion.promotions']}}
{{$productOrderCtrl.translations['antibody.pdp.commerceCard.promotion.viewpromo']}}
{{$productOrderCtrl.translations['antibody.pdp.commerceCard.promotion.promocode']}}: {{promo.promoCode}} {{promo.promoTitle}} {{promo.promoDescription}}. {{$productOrderCtrl.translations['antibody.pdp.commerceCard.promotion.learnmore']}}
图: 1 / 3
Lysozyme Antibody (MA5-36114) in IHC (P)



Please note: We are reviewing Western blot images included in the antibody testing data in our catalog, including those provided by third parties. Unless expressly labeled or annotated as “raw-unedited”, Western blot images included in the antibody testing data in our catalog may have been edited, optimized or otherwise adjusted for presentation.
产品信息
MA5-36114
种属反应
已发表种属
宿主/亚型
分类
类型
克隆号
抗原
偶联物
形式
浓度
规格
纯化类型
保存液
内含物
保存条件
运输条件
RRID
靶标信息
This gene encodes human lysozyme, whose natural substrate is the bacterial cell wall peptidoglycan (cleaving the beta[1-4]glycosidic linkages between N-acetylmuramic acid and N-acetylglucosamine). Lysozyme is one of the anti-microbial agents found in human milk, and is also present in spleen, lung, kidney, white blood cells, plasma, saliva, and tears. Missense mutations in LYZ have been identified in heritable renal amyloidosis.
仅用于科研。不用于诊断过程。未经明确授权不得转售。